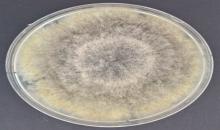

Diplodia bulgarica(DIPBBU)
Photos
All photos included on this page can only be used for educational purposes.
For publication in journals, books or magazines, permission should be obtained from the original photographers with a copy to EPPO.
For publication in journals, books or magazines, permission should be obtained from the original photographers with a copy to EPPO.
6 day old culture of Diplodia bulgarica isolated from Malus domestica in Serbia.
Courtesy: Dr Nataša Duduk (Professor), University of Belgrade
6 day old culture of Diplodia bulgarica isolated from Malus domestica in Serbia.
Courtesy: Dr Nataša Duduk (Professor), University of Belgrade
Purple wood discoloration visible on the cross-section of D. bulgarica infected branch
Courtesy: Hubert Głos
Pycnidia breaking through the bark of a pear tree.
Courtesy: J. Hinrichs-Berger, K. Zegermacher, G. Zgraja (from Hinrichs-Berger et al., 2021)
Old black canker on the limb of an apple tree
Courtesy: J. Hinrichs-Berger, K. Zegermacher, G. Zgraja (from Hinrichs-Berger et al., 2021)







